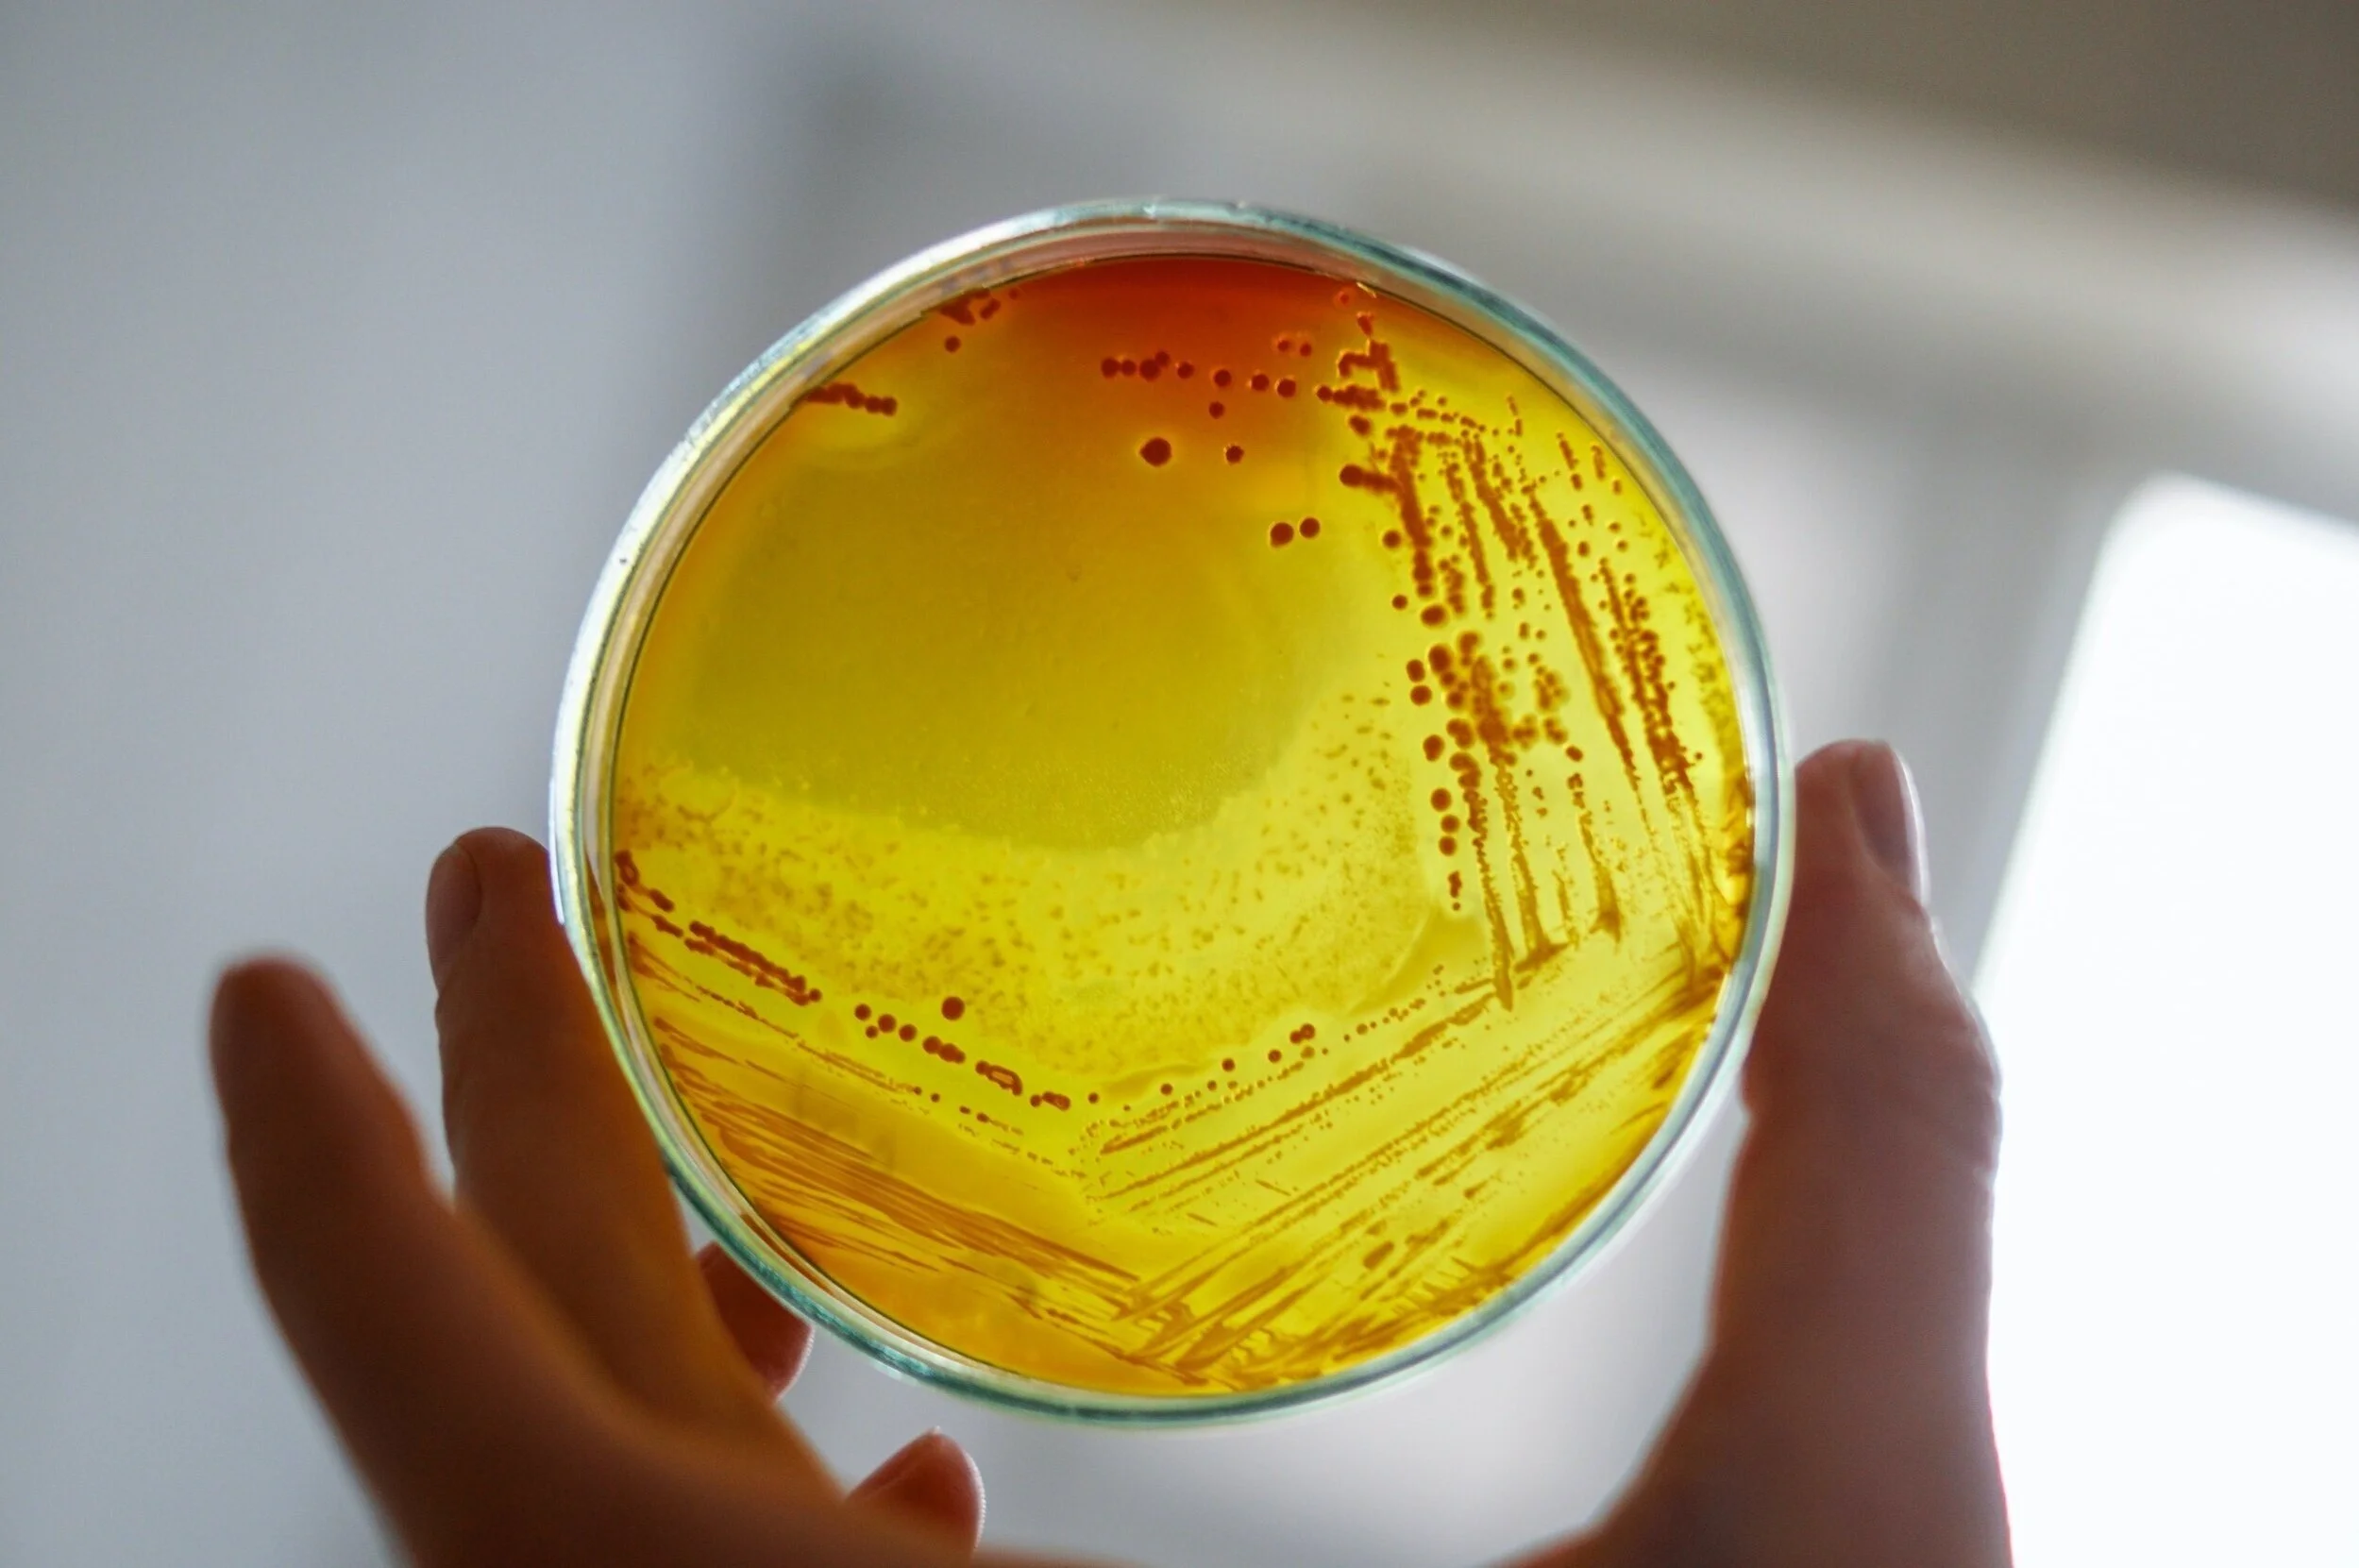

Nos services
CERTILAB produit des rapports précis, remis dans de courts délais. Certaines analyses peuvent être aussi rapides que 24 heures et certaines peuvent prendre jusqu’à 10 jours, selon les paramètres désirés.
Chaque élément analysé a sa propre méthode (microbiologique ou chimique) et nous ne pouvons pas modifier le temps requis pour compléter chacune des analyses.
Cependant notre garantie unique vous assure que les résultats vous seront transmis moins de 24 h faisant suite à l’approbation par le directeur de chacun des laboratoires.
Car nous reconnaissons l’importance de recevoir vos résultats rapidement et notre équipe s’active pour diminuer au minimum votre temps d’attente.
Il est à noter que certaines études demandent des délais plus longs, un traitement informatique plus complexe et même parfois une collaboration multidisciplinaire.
Il est évident que lors d’études de lac, d’air ou lors d’un projet spécifique, il ne s’agit pas de vous donner simplement les résultats. Un rapport détaillé est préparé et, selon le cas, s’ajoute un dossier photographique et les données géo-référencées. Les résultats sont expliquées pour vous permettre d’avoir l’heure juste suivi de recommandations au besoin.
Dans toutes situations, notre engagement demeure le même, vous remettre les résultats des analyses demandées sans attendre.
Vous avez des questions sur la contamination, sur l’impact environnemental, appelez nos experts. Ils répondront à vos questions avec plaisir.
Nous vous référons aussi à la section de la FAQ qui pourra vous diriger vers les services appropriés.
Analyse de l’eau
Nos spécialistes peuvent analyser votre eau afin de s’assurer de sa qualité. Avec l’analyse microbiologique, vous aurez des résultats permettant d’en apprécier la propreté. Avec l’analyse physicochimique, vous aurez un portrait général de la nature de votre eau et pourrez évaluer la pertinence d’installer un système de traitement.
Analyse de l’air
CERTILAB est doté d’une équipe mobile qui analyse l’air de votre domicile afin d’en vérifier la contamination en moisissures et en bactéries. Les spores de levures et les moisissures peuvent avoir des impacts importants sur votre santé. S’assurer de la qualité de l’air d’un domicile, c’est s’assurer du bien-être de toute la famille.
Analyse de sol
Selon les spécifications de firmes d’ingénierie, CERTILAB réalise une analyse du sol afin de le caractériser. À l’aide d’instruments spécifiques, CERTILAB décèle, par exemple, la contamination d’un sol par des produits pétroliers et en fait l’identification. Nous pouvons aussi faire l’analyse pour déceler la présence de l’ocre ferreux.
Le coût des analyses varie en fonction du type d’analyse sélectionné. Les tarifs pour l’année 2026 débutent à 85 $ plus taxes.
Volet biologique
Étude environnementale, faunique, floristique, d’orthophoto et observation microscopique. Avant l’implantation d’un projet immobilier ou d’un projet de développement, certains entrepreneurs souhaitent détenir un rapport d’impact du projet sur l’état des lieux. Une analyse environnementale est donc effectuée afin d’obtenir les autorisations requises par le Ministère de l’Environnement, de la Lutte contre les changements climatiques, de la Faune et des Parcs.
Volet microbiologique
CERTILAB procède à l’analyse de votre eau afin de déterminer si elle contient des micro-organismes, bactéries ou pathogènes nuisibles à votre santé. Cette analyse déterminera si votre eau est potable ou non. Exigés par les banques et les notaires lors de transactions immobilières, des certificats de potabilité sont émis par nos services.
Volet chimique
Nous pouvons aussi déceler la présence d’éléments susceptibles d’affecter le goût, l’apparence physique et l’odeur de l’eau. La composition chimique, les sels minéraux et les métaux sont facilement identifiés par ces analyses.
Contactez-nous!
CERTILAB
154, rue de la Visitation
Saint-Charles-Borromée (Québec) J6E 4N3
Tél. : (450) 755-1255